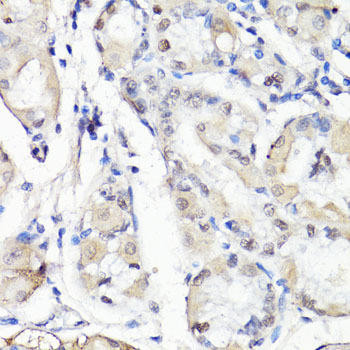
Anti-TBX20 Antibody (CAB15994)

Description
| Antibody Name: | Anti-TBX20 Antibody |
| Antibody SKU: | CAB15994 |
| Antibody Size: | 20uL, 50uL, 100uL |
| Application: | WB IHC |
| Reactivity: | Human, Rat |
| Host Species: | Rabbit |
| Immunogen: | Recombinant fusion protein containing a sequence corresponding to amino acids 1-290 of human TBX20 (NP_001071121.1). |
| Application: | WB IHC |
| Recommended Dilution: | WB 1:500 - 1:2000 IHC 1:50 - 1:200 |
| Reactivity: | Human, Rat |
| Positive Samples: | Rat heart |
| Immunogen: | Recombinant fusion protein containing a sequence corresponding to amino acids 1-290 of human TBX20 (NP_001071121.1). |
| Purification Method: | Affinity purification |
| Storage Buffer: | Store at -20'C. Avoid freeze / thaw cycles. Buffer: PBS with 0.02% sodium azide, 50% glycerol, pH7.3. |
| Isotype: | IgG |
| Sequence: | MEFT ASPK PQLS SRAN AFSI AALM SSGG SKEK EATE NTIK PLEQ FVEK SSCA QPLG ELTS LDAH GEFG GGSG SSPS SSSL CTEP LIPT TPII PSEE MAKI ACSL ETKE LWDK FHEL GTEM IITK SGRR MFPT IRVS FSGV DPEA KYIV LMDI VPVD NKRY RYAY HRSS WLVA GKAD PPLP ARLY VHPD SPFT GEQL LKQM VSFE KVKL TNNE LDQH GHII LNSM HKYQ PRVH IIKK KDHT ASLL NLKS EEFR TFIF PETV FTAV TAYQ NQLI TKLK IDSN PFAK GFRD SS |
| Gene ID: | 57057 |
| Uniprot: | Q9UMR3 |
| Cellular Location: | |
| Calculated MW: | 49kDa |
| Observed MW: | 56kDa |
| Synonyms: | TBX20, ASD4, T-box 20 |
| Background: | This gene encodes a T-box family member. The T-box family members share a common DNA binding domain, termed the T-box, and they are transcription factors involved in the regulation of developmental processes. This gene is essential for heart development. Mutations in this gene are associated with diverse cardiac pathologies, including defects in septation, valvulogenesis and cardiomyopathy. Alternatively spliced transcript variants encoding different isoforms have been found for this gene. |
| UniProt Protein Function: | TBX20: Probable transcriptional regulator involved in developmental processes. Defects in TBX20 are the cause of atrial septal defect type 4 (ASD4). ASD4 is a congenital heart malformation characterized by incomplete closure of the wall between the atria resulting in blood flow from the left to the right atria. ASD4 patients show other heart abnormalities including defects in septation, chamber growth and valvulogenesis. ASD4 is not associated with defects in the cardiac conduction system or with non-cardiac abnormalities. |
| UniProt Protein Details: | Protein type:DNA-binding; Transcription factor Chromosomal Location of Human Ortholog: 7p14.3 Cellular Component: cytoplasm; nucleus Molecular Function:transcription factor activity Biological Process: transcription, DNA-dependent; blood circulation; lateral mesoderm formation; neuron migration; negative regulation of transcription from RNA polymerase II promoter; patterning of blood vessels; cell proliferation; visceral motor neuron differentiation; muscle contraction; dorsal/ventral pattern formation; endoderm formation; cardiac muscle morphogensis; positive regulation of transcription from RNA polymerase II promoter; heart looping; negative regulation of transcription, DNA-dependent; positive regulation of cardiac muscle cell proliferation Disease: Atrial Septal Defect 4 |
| NCBI Summary: | This gene encodes a T-box family member. The T-box family members share a common DNA binding domain, termed the T-box, and they are transcription factors involved in the regulation of developmental processes. This gene is essential for heart development. Mutations in this gene are associated with diverse cardiac pathologies, including defects in septation, valvulogenesis and cardiomyopathy. Alternatively spliced transcript variants encoding different isoforms have been found for this gene. [provided by RefSeq, Oct 2009] |
| UniProt Code: | Q9UMR3 |
| NCBI GenInfo Identifier: | 261337146 |
| NCBI Gene ID: | 57057 |
| NCBI Accession: | NP_001159692.1 |
| UniProt Secondary Accession: | Q9UMR3,Q000T4, Q0IJ70, Q0VAS1, Q9Y2N5, A4D1Y6, |
| UniProt Related Accession: | Q9UMR3 |
| Molecular Weight: | 49,232 Da |
| NCBI Full Name: | T-box transcription factor TBX20 isoform 2 |
| NCBI Synonym Full Names: | T-box 20 |
| NCBI Official Symbol: | TBX20 |
| NCBI Official Synonym Symbols: | ASD4 |
| NCBI Protein Information: | T-box transcription factor TBX20; T-box protein 20 |
| UniProt Protein Name: | T-box transcription factor TBX20 |
| Protein Family: | T-box transcription factor |
| UniProt Gene Name: | TBX20 |
| UniProt Entry Name: | TBX20_HUMAN |
Additional Information
Product Type: |
Antibody |
Reactivity: |
Human |
Reactivity: |
Rat |
Host Species: |
Rabbit |
Isotype: |
IgG |
Antibody Type: |
Polyclonal Antibody |
Research Area: |
Epigenetics and Nuclear Signaling |